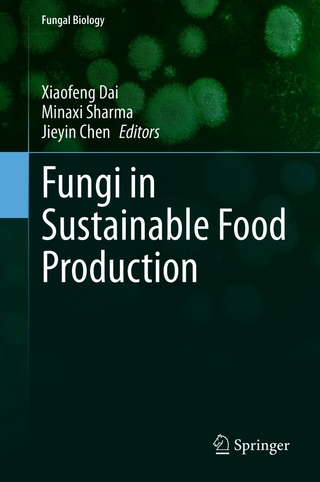
Fungi in Sustainable Food Production

eBook Download (EPUB)
2021
|
Auflage:
1
|
Elsevier Science
ISBN: 9780323884464
155,54 €
(CHF 149,95) (inkl. MwSt)
(CHF 149,95) (inkl. MwSt)
- Download sofort lieferbar